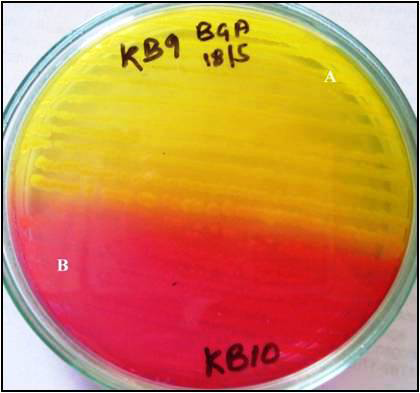

Journal of
eISSN: 2377-4312


Research Article Volume 3 Issue 5
Department of Veterinary Microbiology, College of Veterinary Science & Animal Husbandry, India
Correspondence: Ritu Agrawal, Department of Veterinary Microbiology, College of Veterinary Science & Animal Husbandry, Anjora, Durg (Chhattisgarh), India-491001
Received: June 01, 2016 | Published: August 2, 2016
Citation: Agrawal R, Hirpurkar SD. Prevalence of Salmonella spp. on exterior and interior of fertile eggs from vaccinated breeding hens of different breeds. J Dairy Vet Anim Res. 2016;3(5):178-183. DOI: 10.15406/jdvar.2016.03.00095
Aim: To study prevalence and distribution of Salmonella serotypes on exterior and interior of fertile eggs from four different breeds of poultry and to assess the antibiotic drug resistant pattern of isolates.
Material and Methods: Egg samples were taken on random basis from exterior and interior of eggs from four different breeds of poultry viz. Vanaraja, Gramapriya, Black Rock and Kalinga Brown reared at govt. Poultry Farm, Durg (CG). Samples were processed for isolation of Salmonella spp. using selective enrichment media (Rappaport Vassiliadis Medium) and differential media (MacConkey Lactose Agar) and selective media (Brilliant Green Agar). Isolates were identified by standard biochemical tests and characterized by serotyping using antisera specific for O and H antigen. Each of the isolates was tested for their sensitivity to different antibiotics using disc diffusion method.
Results: Breed wise cultural prevalence of Salmonella serotypes was highest (41%) in Vanaraja and Gramapriya followed by 33% in Kalinga Brown and 25% in BlackRock. Out of 17 total isolates, 16 were recorded as S. Enteritidis and one as S. Typhimurium. Antibiogram of most prevalent Salmonella isolates on the farm revealed that Ciprofloxacin and Enrofloxacin was most effective (100% sensitive) followed by Chloramphenicol (64% sensitive) while all isolates showed resistance to Amoxicillin and Cephalexin.
Conclusion: Higher prevalence of Salmonella serotypes was recorded in fertile eggs of poultry. Salmonella serotypes included S. Enteritidis and S. Typhimurium.
Keywords: prevalence, salmonella, fertile eggs, poultry breed, antibiogram
Salmonellosis is one of the most common infections of poultry and other host species including human. It causes food borne diseases in humans when eggs may get contaminated by horizontal or vertical contamination.1 Salmonella have been known to cause illnesses for more than 100 years and are Gram negative bacilli belonging to the Family Enterobacteriaceae. Like most Enterobacteriaceae they are motile, nonspore forming and facultative anaerobes that reduce nitrates to nitrites, ferment glucose, and are oxidase negative.2 Among the serovars, Salmonella enterica subspecies enterica serovar Enteritidis and Salmonella enterica subspecies enterica serovar Typhimurium can bind to isthmal secretions and can be incorporated into egg during formation. Eggshells and associated membranes have been found to be a frequent site of S. Enteritidis and S.Typhimurium contamination after naturally and experimentally induced Salmonella infections.3 Egg contents may also become contaminated with Salmonella from soiling of the shell with faeces of infected hens, either by direct penetration of the shell or on breaking the eggs. In light of diverse modes of transmission, possibility of ‘superinfection’, complex mechanism of pathogenesis and antigenic diversity, the study about cultural prevalence which includes isolation, identification and characterization of Salmonella in the flock carries greater significance. Generally advanced poultry production practice promises full protection by immunization which is cleverly designed by combination of breeder hen vaccination and active immunization of chicks at appropriate age during early life. Despite of moderate to high percentage of seropositivity due to efficient active immune response to Salmonella vaccine administered to the breeding hens, cultural prevalence of Salmonella have been recorded from eggs.4,5 In recent years, the rapid emergence of multidrug resistance bacteria caused by the wide application of antibiotics in clinical practices has caused great difficulties in medical treatment.6 There are many recent literatures on antibiogram of Salmonella isolates7‒9 showing different resistance patterns of Salmonella spp. to different antibiotics and importance of it in emergence of multiple drug resistance. To foresight and formulate strategic measures for the control and proper treatment of vertically transmitted disease like salmonellosis in a commercial poultry flock, the present study was planned to investigate the rate of re-occurrence and comparative prevalence of salmonellosis in actively immunized breeding hens of four breeds viz. Vanaraja, Gramapriya, Black Rock and Kalinga brown.
Present study included 48 laying hens (40-60weeks of age) from twelve each of four breeds of poultry viz. Vanaraja, Gramapriya, Black Rock and Kalinga Brown reared under optimum management condition at Government Poultry Farm, Durg (Chhattisgarh). These hens were vaccinated with Salmonella polyvalent vaccine inactivated (Venky’s). Twelve eggs from each flock were selected during normal hatching and samples from exterior and interior of eggs were collected on random basis.
Isolation of Salmonella from eggs
The standard methodology10 was used for isolation and identification of Salmonella from exterior surface as well as inner contents of eggs. Egg swabs were taken from the surface of each egg by dipping a sterile swab in normal saline and then swabbing over the surface of egg. The swabs were then dipped in a separate tube containing 5 ml RVM.
Each of the eggs was broken and a drop of egg yolk pipette out to inoculate in RVM for selective enrichment. After incubation for 24hr, tubes showing turbidity were separated and loop full of growth was further streaked on MLA, incubated at 37oC for 24hr. Lactose fermenting (pink colonies) and non lactose fermenting (colourless colonies) organisms were identified. The Salmonella suspected non lactose fermenting colonies were picked up and streaked on BGA. The plates were incubated at 37oC for 24hr. The isolated single colony appeared pink on BGA. A pure culture on nutrient agar slants was preserved at 40C till further processing.
Identification and characterization of Salmonella isolates
All the isolates suspected as Salmonella spp. were further identified on the basis of Gram staining, motility and biochemical characters. Gram staining and motility test was performed on each isolate and observations were considered for presumptive identification for Salmonella spp. Each of the isolates was further identified on the basis of series of biochemical tests viz. Indole production, Methyl red, Voges-proskauer and Citrate utilization.11 Observations about the set of biochemical tests; Citrate utilization test and pattern of growth in Triple sugar iron agar slant (TSI) were further considered for final identification of Salmonella up to the species level. On Simmon’s citrate agar each inoculums from pure culture was streaked and subsequent after 72hours incubation at 370C, these slants were observed for change of colour from green to blue. Similarly isolates were inoculated on the TSI agar slants by stab culture method into the butt and incubated aerobically at 37oC for 24hr. TSI isolates were serotyped by slide agglutination test using commercially available antisera specific for O and H antigens of S. Typhimurium and S. Enteritidis.
Antibiogram of isolates
Each of the isolates was tested for their sensitivity to different antibiotics as per method described by Bauer et al.12 Commercially available antibiotics discs (Himedia, Laboratories Limited, Mumbai) were used to test sensitivity of isolates against the antibiotics. Antibiotics discs included Amoxicillin, Chloramphenicol, Chlortetracycline, Ciprofloxacin, Cephalexin, Doxycycline, Enrofloxacin, Furazolidone, and Sulphadiazine. From the pure culture a loop full of culture was inoculated into 5.0ml of nutrient broth and incubated at 370C for 18hr. The inoculum was spread over the Muller and Hinton agar plates with the help of sterile swab and left for 20min in incubator for absorption of culture. The antibiotic discs were placed at equal distance with the help of pointed forceps without touching to surface of agar. After overnight incubation, diameter (mm) of zone of inhibition (if any) was measured using Hi antibiotics Zone scale (Himedia) and susceptibility of isolates to antibiotic was recorded.
Isolation and identification of Salmonellaspp.
Based on primary culture or enrichment in RVM (Figure 1) followed by differentiation on MLA (Figure 2) and specific growth characters on BGA (Figure 3), isolates were presumptively identified as Salmonellaspp. On Gram’s staining isolates showed presence of small Gram negative coccobacillus (Figure 4); were motile (Figure 5) and found positive for methyl red and citrate utilization test (Figure 6) however showed negative result with indole production and Voges-proskauer. Based on cultural characteristics and biochemical properties, isolates were confirmed as Salmonellaspp. On TSI, One isolates showed black precipitates (more H2S production) throughout media with less alkaline reaction on slant (indicative of S. Typhimurium), however 16 isolates (suspected for S. Enteritidis) produced black precipitate over slant surface only with red slant and yellow butt (Figure 7). Using antiserum specific for O and H antigens, 16 isolates were identified as S. Enteritidis and one as S. Typhimurium.
Prevalence of Salmonellaserotypes
35.4% (17 out of 48) egg samples were found positive for Salmonellaspp. Exterior and interior of the eggs showed 14.5 and 20.8% cultural prevalence of Salmonellaspp., respectively. Of total isolates (35.4%), 33.3% included S. Enteritidis and 2.08% belongs to S. Typhimurium. Prevalence rate was higher in Vanaraja and Gramapriya breed (41.6%) followed by Kalinga Brown (33.3) and Black Rock (25%). Breed wise and serotype wise distribution of Salmonellaon exterior and interior of eggs are depicted in Table 1 & 2.
Breed |
No. of samples tested |
No. of samples positive for Salmonella |
||
Salmonella Enteritidis |
Salmonella Typhimurium |
Total positive (per cent) |
||
Vanaraja |
12 |
1 |
- |
1(8.3) |
Gramapriya |
12 |
2 |
1 |
3(25) |
Black Rock |
12 |
3 |
- |
3(25) |
Kalinga Brown |
12 |
- |
- |
- |
Total |
48 |
6 |
1 |
7(14.5) |
Table 1 Distribution of Salmonella serotype on exterior of eggs
Breed |
No. of samples tested |
No. of samples positive for Salmonella |
||
Salmonella Enteritidis |
Salmonella Typhimurium |
Total positive (per cent) |
||
Vanaraja |
12 |
4 |
- |
4(33.3) |
Gramapriya |
12 |
2 |
- |
2(16.6) |
Black Rock |
12 |
- |
- |
- |
Kalinga Brown |
12 |
4 |
- |
4(33.3) |
Total |
48 |
10 |
- |
10(20.8) |
Table 2 Distribution of Salmonella serotype in interior of eggs
Antibiogram profile of Salmonellaisolates
In the present study 100% isolates were found highly sensitive to Ciprofloxacin and Enrofloxacin (Figure 8) followed by Chloramphenicol (64%). All isolates of Salmonellawere resistant to Amoxicillin and Cephalexin followed by Doxycycline and Furazolidone (88.23%), Sulphadiazine (76.4%) and Chlortetracycline (64%).
Isolation of Salmonella from eggs possesses great importance as they may lead to spread of Salmonella in hatchery. Breeder and broiler hatcheries were highly contaminated with salmonellae because many eggs coming from a naturally infected flock and even a single Salmonella positive egg can increase the contamination.13 Eggs inoculated with high numbers of S. Typhimurium still hatch and upon hatch, the Salmonella is widely disseminated through the hatching cabinet due to fan-forced air and most (>80%) of the chicks hatched in trays both above and below inoculated eggs were positive for an antibiotic-resistant marker strain of S. Typhimurium.14 In another study, Cason et al.15 showed that eggs carrying Salmonella on the exterior or in shell membranes could lead to contamination of the chick at the pipping of the eggshell.15 Thus even single positive Salmonella infected egg is of great importance in contaminating the whole flock. Eggshells and associated membranes have been found to be a frequent site of Enteritidis and Typhimurium contamination after naturally and experimentally induced Salmonella infections.3
In a study, relatively higher (49.5 %) cultural prevalence of Salmonella from live and dead birds was reported,4 which might be due to the differences in environmental, managemental and geographical distribution. The percentage isolation rate of S. Typhimurium in present study (2.08%) is in agreement with the finding of Nagappa et al.,16 who reported 1.5% prevalence. The slight variation may be attributed to previous exposure history to S. Typhimurium which may had imparted immunity to the hens under study.
Prevalence of Salmonella serotypes in eggs from vaccinated hen could be explained. Presence or absence of antibody in the blood is not directly related with the presence of bacteria in the reproductive or digestive tract which further get transmitted to egg yolk and egg surface, respectively. Our findings are in accordance with the findings earlier reported by Ahmed et al.,4 who have reported 71% cultural prevalence from cloacal swabs in seropositive birds and 59 per cent in seronegative birds.4 Higher cultural prevalence in seropositve birds than seronegative birds could be due to repeated exposure of hens to Salmonella infection along with continuous antibiotic treatment in all ages of birds. Similarly, in a report 66% of Salmonella was recorded in seropositive group.5 Present study was supported by a study, in which it was reported that only 80% hens vaccinated with S. Enteritidis vaccines survived through passive protection against Salmonella enterica serovar Enteritidis infection from maternally derived antibodies.17 Higher cultural prevalence of Salmonellae in present study may be due to less effectiveness of solely used inactivated vaccines. The facts was supported by Dorea et al.,18 and Innoue et al.,19 who observed that passive immunity to progeny chicks has been exploited as an intervention to break the chain of infection vertically against salmonellae by vaccinating breeders with a combination of both live and killed Salmonella vaccines. Use of a live Salmonella vaccine to prevent colonization of the gut early by wild-type salmonellae and to reduce shedding of the organisms will effectively control spread and the prevalence of salmonellae in poultry.20
The widespread use of antimicrobial agents in food-animal production has contributed to the decreased susceptibility of Salmonella to antibiotics showing 91% multidrug resistance, which can be transmitted to humans through food of animal origin21 and thus frequent antibiotic treatment may precede the emergence of antibiotic resistant strains of Salmonella spp. (Indicriminate use of antibiotics in the field without knowing the culture sensitivity increases the risk of developing multidrug resistance Salmonella spp. So antibiotics must be used very judiciously to lower the development of multidrug resistance Salmonella serotpyes.) Antibiotic sensitivity pattern in present study correlates with the observation of Kumar et al.,22 who reported Ciprofloxacin sensitive Salmonella isolates. The results in present study are at par with the results reported by Chao et al.,23 who reported increased resistance of Salmonella Typhimurium strains to Doxycycline, Colistin, Sulfamethoxazole- trimethoprim and Cephalothin. Increased resistance of Salmonella to different antibiotics was also supported by Yan et al.,24 who detected multidrug resistant genes in 177 isolates of S. Enteritidis.24
Looking to the higher cultural prevalence of Salmonella serotypes in vaccinated breeding hens (Because of higher cultural prevalence of Salmonella serotypes inspite of vaccination, throws a light that the immunity provided by the vaccine is not sufficient enough which may be due to age of the birds, vaccination schedule etc, which supports the prevalence of Salmonella serotypes in breeding hens) further study is to be needed regarding rate of maternal transfer of immunoglobulin to progeny chick. (High level of maternal transfer of immunoglobulin to progeny chick via egg will confer resistance against Salmonella in both eggs and chicks) multidrug resistant Salmonella serotypes in present study explore the indiscriminate use of antibiotics in poultry flock. (Frequent usage of antibiotics in the poultry flock may have lead to development of multidrug resistance Salmonella spp.) A range of interventions should be implemented in addition to vaccination to control salmonellosis including biosecurity, pest and rodent control, judicious use of antibiotics and competitive exclusion with probiotics. (Because of presence of multidrug resistance Salmonella serotypes in present study in spite of vaccination, needs more measures to check the occurrence of Salmonellosis in Poultry flock which can be done by increasing biosecurity measures, controlled and judicious use of antibiotics etc).
The authors are highly thankful to the Manager, Govt. Poultry Farm, Durg (Chhattisgarh) for providing fertile eggs during this study.
Author declares that there is no conflict of interest.

©2016 Agrawal, et al. This is an open access article distributed under the terms of the, which permits unrestricted use, distribution, and build upon your work non-commercially.